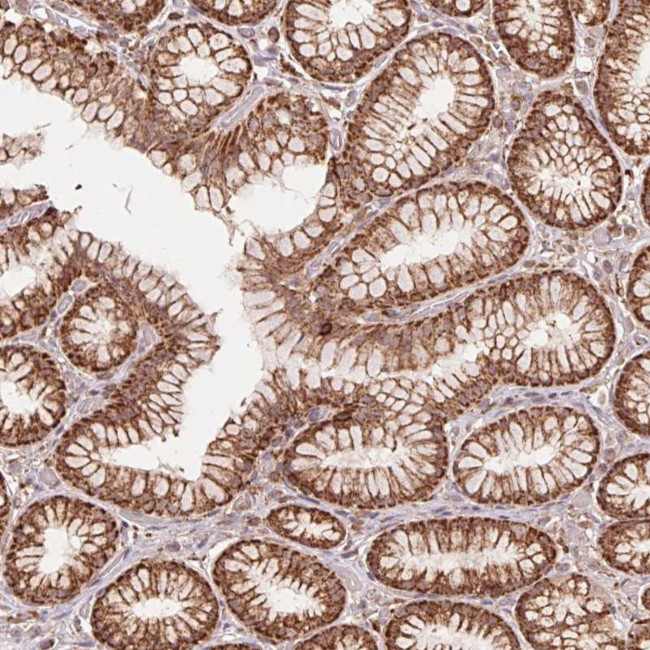
URM1 Antibody in Immunohistochemistry (Paraffin) (IHC (P))

Search
Invitrogen
URM1 Polyclonal Antibody
{{$productOrderCtrl.translations['antibody.pdp.commerceCard.promotion.promotions']}}
{{$productOrderCtrl.translations['antibody.pdp.commerceCard.promotion.viewpromo']}}
{{$productOrderCtrl.translations['antibody.pdp.commerceCard.promotion.promocode']}}: {{promo.promoCode}} {{promo.promoTitle}} {{promo.promoDescription}}. {{$productOrderCtrl.translations['antibody.pdp.commerceCard.promotion.learnmore']}}
产品信息
PA5-64201
种属反应
宿主/亚型
分类
类型
偶联物
形式
浓度
规格
纯化类型
保存液
内含物
保存条件
运输条件
RRID
产品详细信息
Immunogen sequence: SVEVEFGGGA ELLFDGIKKH RVTLPGQEEP WDIRNLLIWI KKNLLKERPE LFIQGDSVRP GILVLINDAD WELLGELDYQ LQDQDSVLFI STLHG
Highest antigen sequence identity to the following orthologs: Mouse - 93%, Rat - 94%.
靶标信息
Following the discovery of protein modification by the small, highly conserved ubiquitin polypeptide, a number of distinct ubiquitin-like proteins (Ubls) have been found to function as protein modifiers as well. These Ubls, which include SUMO, ISG15, Nedd8, and Atg8, function as critical regulators of many cellular processes, including transcription, DNA repair, signal transduction, autophagy, and cell-cycle control. A growing body of data also implicates the dysregulation of Ubl-substrate modification and mutations in the Ubl-conjugation machinery in the etiology and progression of a number of human diseases. URM1 is a ubiquitin-like modifier protein.
仅用于科研。不用于诊断过程。未经明确授权不得转售。
篇参考文献 (0)
生物信息学
蛋白别名: MGC2668; RP11-339B21.4; Ubiquitin-related modifier 1; ubiquitin-related modifier 1 homolog; unnamed protein product
基因别名: C9orf74; URM1
UniProt ID: (Human) Q9BTM9
Entrez Gene ID: (Human) 81605